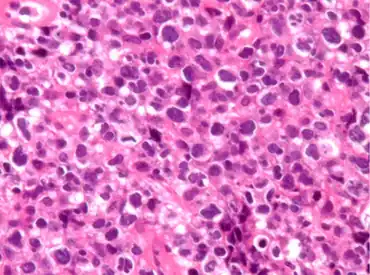

Primary mediastinal (thymic) large B cell lymphoma
| Primary mediastinal (thymic) large B cell lymphoma | |
|---|---|
| Other names: Mediastinal large B cell lymphoma, primary mediastinal large B-cell lymphoma (PMLBCL), mediastinal large B-cell lymphoma | |
![]() | |
| Pathological features observed during staining. | |
| Specialty | Hematology, oncology |
Primary mediastinal (thymic) large B-cell lymphoma is a distinct type of diffuse large B-cell lymphoma involving the mediastinum, recognized in the WHO 2008 classification.[1][2]: 370–374
Signs and symptoms
Superior vena cava syndrome occurs in 30–50%, and pleural or pericardial effusions occur in about one-third.[3]
Pathophysiology
PMLBCL arises from a putative thymic peripheral B cell.[3][4] It has several distinctive biological features.[3] Molecular analysis shows that PMLBCL is distinct from other types of diffuse large B-cell lymphomas (DLBCL).[4] MAL gene expression is seen in 70%, unlike other diffuse large B-cell lymphomas.[2]: 370 Gene expression profiling shows considerable variance from other DLBCLs and similarity to Hodgkin disease.[5]: 290–293
PMLBCL is CD20 positive, expresses pan-B markers including CD79a, and has clonal immunoglobulin gene rearrangements and mRNA but paradoxically does not express cytoplasmic or cell surface immunoglobulin.[2]: 370
Clinically, PMLBCL is unusual in several respects. Despite 80% PMLBCL being stage I or II, the presenting anterior mediastinal mass is often over 10 cm and is locally invasive of lung, chest wall, pleura, and pericardium.[3] At initial presentation, PMLBCL is usually confined to mediastinum, but its bulk, rather than additional adenopathy, can sometimes be palpated at the low neck.[3] Increased LDH is seen in approximately 75%,[2]: 370 [3] but unlike other large cell lymphomas, no increase in beta-2 microglobulin is seen even when bulky[2]: 370 which may relate to defective major histocompatibility complex expression.[2]: 370
Diagnosis
The diagnosis of this condition is done via the following:[6]
- Mediastinoscopy or
- Percutaneous CT-guided core needle biopsies
Differential diagnosis
The DDx of this condition is as follows:[6]
Treatment
Multiagent chemotherapy is recommended, but the preferred regimen is controversial, as is consolidative radiotherapy.[3][7][10][6]
Epidemiology
It affects primarily young adults; the median age is 37 years.[2]: 370 It is more common in females.[3]
See also
References
- ↑ Swerdlow, Steven H.; International Agency for Research on Cancer; World Health Organization (2008). WHO classification of tumours of haematopoietic and lymphoid tissues. World Health Organization classification of tumours. Vol. 2 (4th ed.). International Agency for Research on Cancer. ISBN 9789283224310. Archived from the original on 2015-02-11. Retrieved 2021-03-23. Archived 2015-02-11 at the Wayback Machine
- ↑ 2.0 2.1 2.2 2.3 2.4 2.5 2.6 Jaffe, ES; Harris NL; Vardiman JW; Campo E; Arber DA (2011). Hematopathology (1st ed.). Elsevier Saunders. ISBN 9780721600406.
- ↑ 3.0 3.1 3.2 3.3 3.4 3.5 3.6 3.7 3.8 Armitage, JO; Mauch PM; Harris NL; et al. (2010). "Chapter 21". Non-Hodgkin Lymphomas (2nd ed.). Lippincott Williams & Wilkins. ISBN 9780781791168.
- ↑ 4.0 4.1 Martelli M, Di Rocco A, Russo E, et al. (2015). "Primary mediastinal lymphoma: diagnosis and treatment options". Expert Rev Hematol. 8 (2): 173–86. doi:10.1586/17474086.2015.994604. hdl:11573/780924. PMID 25537750. S2CID 23040185.
- ↑ Sweetenham, J. Lymphomas (Emerging Cancer Therapeutics V3 I2). Demos. November 2, 2012. ISBN 9781936287789
- ↑ 6.0 6.1 6.2 Dabrowska-Iwanicka, Anna; Walewski, Jan A. (2014). "Primary Mediastinal Large B-cell Lymphoma". Current Hematologic Malignancy Reports. 9 (3): 273–283. doi:10.1007/s11899-014-0219-0. ISSN 1558-8211. Archived from the original on 12 February 2022. Retrieved 11 February 2022. Archived 12 February 2022 at the Wayback Machine
- ↑ 7.0 7.1 "Archive copy" (PDF). Archived (PDF) from the original on 2017-06-23. Retrieved 2021-03-23.
{{cite web}}: CS1 maint: archived copy as title (link) Archived 2017-06-23 at the Wayback Machine - ↑ Hutchinson CB, Wang E (2011). "Primary mediastinal (thymic) large B-cell lymphoma: a short review with brief discussion of mediastinal gray zone lymphoma". Arch. Pathol. Lab. Med. 135 (3): 394–8. doi:10.5858/2009-0463-RSR.1. PMID 21366467.
- ↑ Grant C, Dunleavy K, Eberle FC, et al. (2011). "Primary mediastinal large B-cell lymphoma, classic Hodgkin lymphoma presenting in the mediastinum, and mediastinal gray zone lymphoma: what is the oncologist to do?". Curr Hematol Malig Rep. 6 (3): 157–63. doi:10.1007/s11899-011-0090-1. PMC 6324553. PMID 21590365.
- ↑ Faris JE, LaCasce AS (2009). "Primary mediastinal large B-cell lymphoma". Clin Adv Hematol Oncol. 7 (2): 125–33. PMID 19367254.
External links
| Classification |
|
|---|